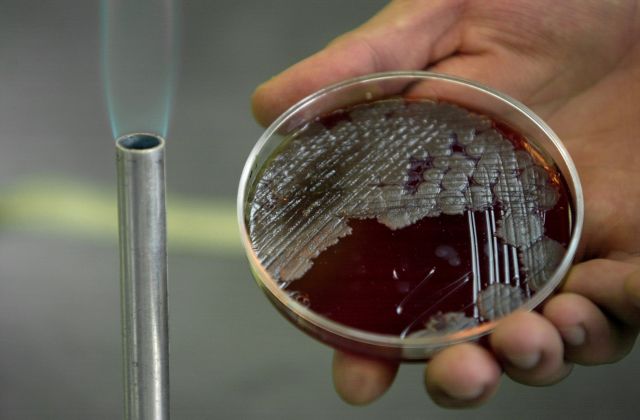
Κυτταρικές καλλιέργειες, νέο υποψήφιο όπλο κατά του καρκίνου

Αναγνώριση για την προσφορά της αθάνατης Χενριέτα Λακς
Χιλιάδες ιατρικές μελέτες έχουν πραγματοποιηθεί ως σήμερα με κύτταρα HeLa, κύτταρα τα οποία προήλθαν από μια φτωχή αφροαμερικανίδα που πέθανε από καρκίνο το 1951. Εξήντα χρόνια μετά, η οικογένεια της Χενριέτα Λακς κατέληξε σε συμφωνία με την αμερικανική κυβέρνηση για τη χρήση των πολύτιμων γενετικών δεδομένων.

Αριθμός Πιστοποίησης Μ.Η.Τ.232442
Αριθμός Πιστοποίησης Μ.Η.Τ.232442